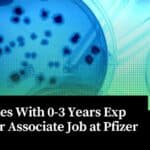
Microbiology Jobs Pfizer 2023

Home Search
microbiology - search results
If you're not happy with the results, please do another search
CDFD Research Scholars Program 2023 (RSP – II – 2023), Apply Online
CDFD 2023 Research Scholars Program (RSP - II - 2023), Apply Online
CDFD 2023 Research Scholars Program (RSP - II - 2023), Apply Online CDFD...
IIT Jodhpur-TiSC BIRAC-BIG Project Technical Assistant Job For MSc & BTech Candidates
IIT Jodhpur-TiSC Project Technical Assistant Job For MSc & BTech Candidates
IIT Jodhpur-TiSC Project Technical Assistant Job For MSc & BTech Candidates. IIT Jodhpur-TiSC job...
Syngene BSc Life Sciences Job Opportunity, Apply Online
Syngene BSc Lab Jobs - BSc Life Sciences Apply Online
Syngene BSc Lab Jobs - BSc Life Sciences Apply Online. BSc Life Sciences Job in...
Biotech Research Career Roadmap For Graduates & Post Graduate Students
Biotech Research Career Roadmap - The field of biotechnology has been rapidly advancing in recent years, with new discoveries and innovations driving growth and...
Biotecnika Times Newsletter 30.03.2023 DRDO Jobs, Lilly Intern, Baxter, Cargill Hiring
Biotecnika Times Newsletter 30.03.2023 DRDO Jobs, Lilly Intern, Baxter, Cargill Hiring
5+ DRDO-INMAS JRF Jobs For MSc, MTech, BTech Biotech, Biochem, Bioinformatics, Life Sciences, Mol...
Biotecnika Times Newsletter 29.03.2023 Govt CDSCO Jobs, DBT-inSTEM PhD Admissions, CUET UG Last Date...
Biotecnika Times Newsletter 29.03.2023 Govt CDSCO Jobs, DBT-inSTEM PhD Admissions, CUET UG Last Date Approaching
Govt CDSCO Job Openings For Microbiology Candidates, Applications Invited
Govt CDSCO...
Biotecnika Times Newsletter 28.03.2023 Summer Research Program, Govt Jobs, NCCS Pune PhD, Career Guidance...
Biotecnika Times Newsletter 28.03.2023 Summer Research Program, Govt Jobs, NCCS Pune PhD, Career Guidance by Shekhar Suman
Summer Research Program 2023 at IISER Mohali -...
IISER Pune Life sciences / Biotechnology MSc, MTech Research Fellow Job
IISER Pune Life sciences / Biotechnology MSc, MTech Research Fellow Job
IISER Pune Life sciences / Biotechnology MSc, MTech Research Fellow Job. Junior Research Fellow...
Biotecnika Times Newsletter 27.03.2023 NCBS Graduate Trainee Opportunity, IISER Bhopal Internship
Biotecnika Times Newsletter 27.03.2023 NCBS Graduate Trainee Opportunity, IISER Bhopal Internship
NCBS Graduate Trainee Opportunity For MSc Bioinformatics, Biotech & Life Sciences
NCBS Graduate Trainee Job...
NCBS Graduate Trainee Opportunity For MSc Bioinformatics, Biotech & Life Sciences
NCBS Graduate Trainee Job For MSc Bioinformatics, Biotech & Life Sciences
NCBS Graduate Trainee Job For MSc Bioinformatics, Biotech & Life Sciences. MSc Bioinformatics, Biotech...
NIMHANS Multiple Research Fellow Jobs For MSc Candidates From Varied Life Sciences Backgrounds
NIMHANS Research Fellow Jobs For MSc Candidates From Varied Life Sciences Backgrounds
NIMHANS Research Fellow Jobs For MSc Candidates From Varied Life Sciences Backgrounds. MSc...
Labcorp Biological Sciences Medical Lab Tech Job, Online Application Process
Labcorp Biological Sciences Medical Lab Tech Job, Online Application Process
Labcorp Biological Sciences Medical Lab Tech Job, Online Application Process. BSc biological sciences job opening....
Biotecnika Times Newsletter 24.03.2023 Govt NIFTEM, SSC Jobs, CSIR NET Notes + Much More
Biotecnika Times Newsletter 24.03.2023 Gove NIFTEM, SSC Jobs, CSIR NET Notes + Much More
25+ Govt SSC Staff Selection Commission Recruitment 2023, Online Application Process
SSC...
Candidates With 0-3 Years Exp Apply For Associate Job at Pfizer
Microbiology Jobs Pfizer 2023 - Candidates With Minimal Exp Can Apply
Microbiology Jobs Pfizer 2023 - Candidates With Minimal Exp Can Apply. Pfizer is hiring...
MSc Life Sciences SRF Job Opening at AIIMS Jodhpur, Attend Walk-In-Interview
AIIMS Jodhpur MSc SRF Job For Life Sciences, Attend Walk-In
AIIMS Jodhpur MSc SRF Job For Life Sciences, Attend Walk-In. Senior Research Fellow job for...